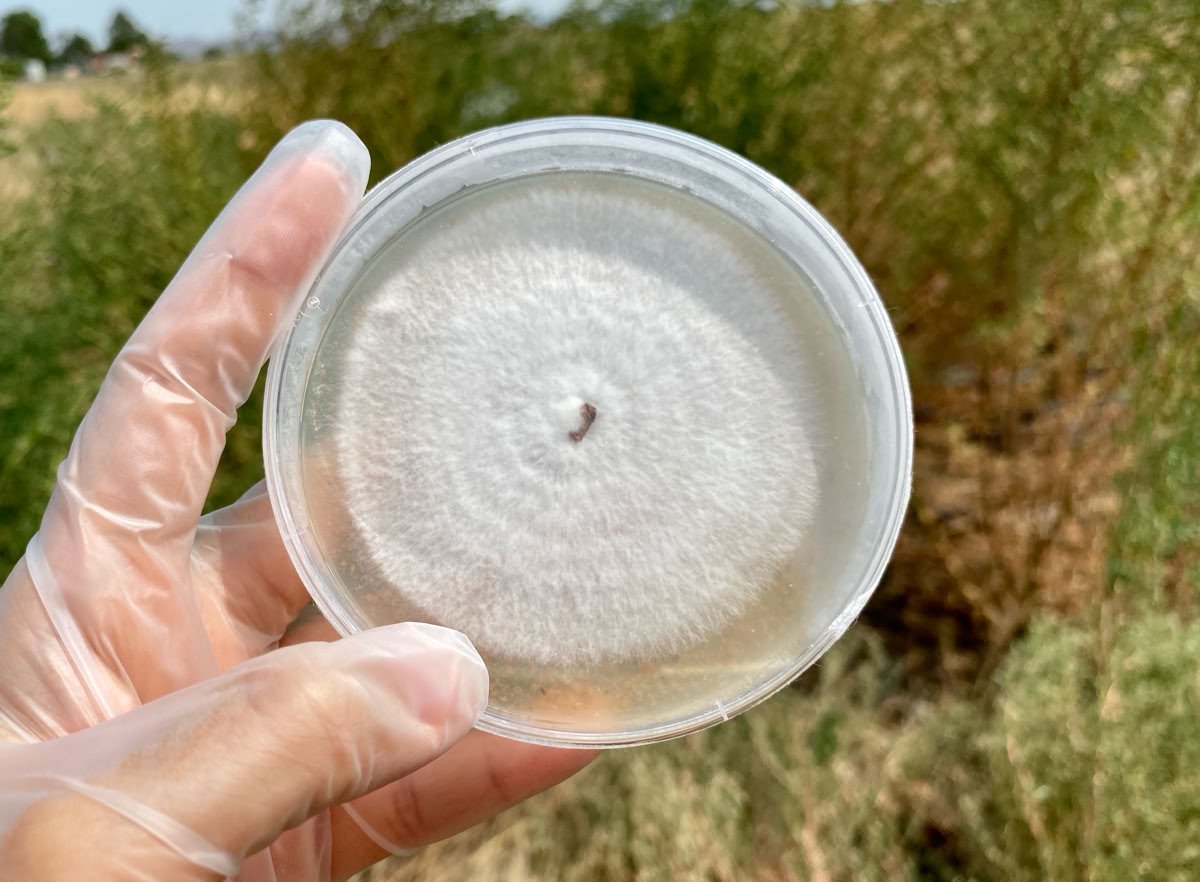
seed

Applying ISO 9001 principles to mushroom production
Request a Growing Contract

OYSTER MEDLEY




SHIITAKE



LION’s MANE



MEDICINAL VARIETIES



MUSHROOM SEEDS
MUSHROOM CLONING

Special subterranean infrastructure allows us a fantastic range of environment simulation and stimulation control.
UNDERGROUND
SPECIALTY
FOR THE LOVE OF GROWING

Growing mushrooms and developing the infrastructure to support repeat output is what we do best.

ISO 9001 STYLE QUALITY MANAGMENT
Sun Again Farm adheres strictly to ISO 9001 standards, we aspire to achieve official certification in a years time.

SUN AGAIN FARM LLC.
200 S Curtis Ave. #706
WILLCOX, AZ 85643-2144
(520) 425-4912
TEXT PREFERED, CALLS ARE SCREENED










